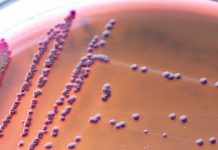
Research: Bacterial armor could be a new target for antibiotics —

Research: Folding polyhedron sampler enables easy capture and release of delicate underwater organisms —
Scientists have tried to find the safest and most effective ways to explore marine life in the oceanic water, the largest and least...
Research: Global study of world’s beaches shows threat to protected areas —
A first-of-its-kind survey of the world's sandy shorelines with satellite data found that they have increased slightly on a global scale over the...
Research: Finding could help inform astronomers’ search for life outside our solar system —
A sample of ancient oxygen, teased out of a 1.4 billion-year-old evaporative lake deposit in Ontario, provides fresh evidence of what the Earth's...
Research: Hurricanes and other extreme events —
The availability of water from underground aquifers is vital to the basic needs of more than 1.5 billion people worldwide.
In recent decades, however,...
Research: Great Barrier Reef not bouncing back as before, but there is hope —
The Great Barrier Reef is losing its ability to recover from disturbances, but effective local management could revive its capacity to bounce back.
Scientists...
Research: Bacterial armor could be a new target for antibiotics —
For over a century, scientists have studied E. coli, one of the bacteria that cause food poisoning, as a model for fighting infections....
Research: Where baby white sharks ‘hang out’ in the North Atlantic —
Using cutting-edge satellite and acoustic technology, a researcher from Florida Atlantic University's Harbor Branch Oceanographic Institute is among a team of scientists who...
Research: New material reversibly changes its structure in response to different wavelengths of light...
MIT researchers have designed a polymer material that can change its structure in response to light, converting from a rigid substance to a...
Research: Atlantic circulation is not collapsing — but as it shifts gears, warming will...
A huge circulation pattern in the Atlantic Ocean took a starring role in the 2004 movie "The Day After Tomorrow." In that fictional...
Research: Results may help identify ancient climates on Earth or other planets —
There are more than 1 million river basins carved into the topography of the United States, each collecting rainwater to feed the rivers...
Top News
Hey ISIS, You Suck: Local Muslims Post Anti-ISIS Billboard
A new billboard on Manchester Road in Missouri reads, "HEY ISIS, YOU SUCK!!! From: #ActualMuslims."
A group of Muslim-Americans have put up a blunt billboard...